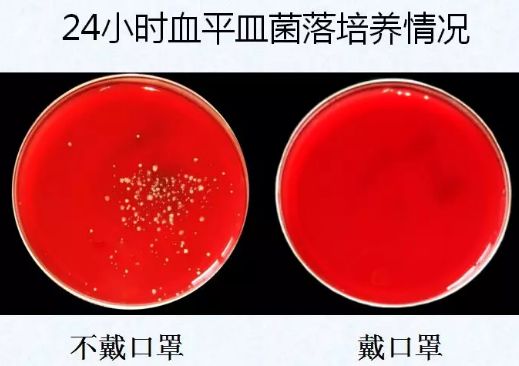

2020-01-29 14:23:09北京市疾控中心
疾控君为您带来预防新型冠状病毒最重要的第三招:
知礼仪
预防新型冠状病毒感染的肺炎
打喷嚏咳嗽产生的飞沫能够传播细菌或病毒,进而传播疾病,即便是健康人打喷嚏和咳嗽,产生的飞沫中也可能携带细菌或病毒!

你知道打喷嚏和咳嗽
产生的飞沫能扩散多远吗?
当我们打喷嚏或咳嗽时,产生的飞沫像一团云迅速扩散,能够把细菌或病毒带到2米左右的距离。

所以为避免细菌或病毒通过飞沫传播,至少需要保持2米的距离。
已经出现咳嗽打喷嚏症状,
如何避免传播给他人?
尽量与他人保持2米以上的距离,如果在人员密集的场所(如在早高峰的地铁上),可以通过佩戴口罩避免传播给他人。

当生病时,无论是去医院就诊还是在家休息,佩戴口罩能够给您和他人安心的防护。
打喷嚏时用手捂住可以吗?
正确的做法是什么?
很多人打喷嚏时都会下意识用手捂住,但其实这是错误的!

在日常生活中,打喷嚏或咳嗽时,可以用纸巾遮掩口鼻。

如果一时情急,来不及准备,可以用肘部衣袖遮掩。

因为肘部接触其他地方的机会少,不容易造成细菌和病毒的散播。
这不仅是防止疾病传播的办法,也是文明素养的表现。
为了你我的健康,请做到:
打喷嚏,掩口鼻,
习礼仪、讲卫生。
中安在线2026-01-03 11:45:22
光明网2026-01-03 11:44:31
【连续报道·报效祖国 建功西部】“任何时候,艰苦奋斗的精神不能丢”
光明网2026-01-03 11:43:43
新质先锋|打造国际绿色经济标杆城市 解读北京的“绿色新风口”
新京报2026-01-03 11:06:10
中国新闻网2026-01-03 10:18:06
中国新闻网2026-01-03 10:17:25
新华社2026-01-03 10:15:28
CCTV42026-01-03 10:12:30
国际观察丨借鉴中国经验 俄远东“新园区”为中俄合作提供新平台
新华网2026-01-03 10:11:24
中国新闻网2026-01-03 10:10:44
央视新闻2026-01-03 10:09:01
“为世界注入更多稳定性与确定性”——访俄罗斯科学院世界经济与国际关系研究所副所长洛马诺夫
人民日报2026-01-03 10:08:19
人民日报2026-01-03 10:07:18
新华网2026-01-03 10:05:48
“沉浸式体验+多元场景”释放假日多彩活力 游客在文化与烟火气中欢度佳节
央视网2026-01-03 10:00:15
央视网2026-01-03 09:58:44
新华社2026-01-03 09:56:50
央视新闻2026-01-03 09:55:44
数说经济 | 顶着压力破浪前行,中国经济靠什么实现“逆袭”?
经济日报2026-01-03 09:54:28
央视新闻2026-01-03 09:53:12
央视网2026-01-03 09:51:18
央视新闻2026-01-03 09:47:46
新华社2026-01-03 09:43:26
央视新闻2026-01-03 09:42:12
新华社2026-01-02 20:59:44
封关运作后首个元旦假期 海口免税消费从“游客型”向“生活圈”延伸
新华社2026-01-02 20:59:12
【“中国游记”第二季⑭】如何获得“中国游”丝滑体验?你需要这三个小“锦囊”
中央广电总台国际在线2026-01-02 20:58:46
中国新闻网2026-01-02 20:58:21
新华网客户端2026-01-02 20:55:45
央视新闻2026-01-02 20:55:09